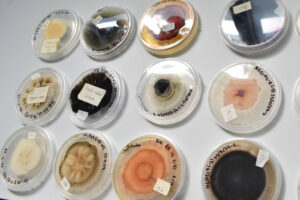

Staff/RG
Detectan hongos, crean un sensor para identificar patógenos y determinan bacterias y levaduras en su proceso de fermentación
Para fortalecer la producción de mezcal en el estado de Puebla, cuya fabricación en 2022 fue cercana a los 500 mil litros, investigadores de la BUAP realizan un proyecto de colaboración con el Instituto Politécnico Nacional (IPN), que involucra la detección de hongos que dañan a la planta, el desarrollo de un biosensor para identificarlos, la determinación de bacterias y levaduras en el proceso de fermentación de esta bebida, hasta el aprovechamiento de residuos y conservación de germoplasma de especies nativas.
Por parte de la Máxima Casa de Estudios en Puebla participan los doctores Vianey Marín Cevada, Liliana López Pliego y Miguel Castañeda Lucio, del Instituto de Ciencias (ICUAP); así como Luis Ramiro Caso Vargas, de la Facultad de Ciencias Biológicas. Además de científicos del Centro Interdisciplinario de Investigación para el Desarrollo Integral Regional (CIIDIR), del IPN, unidades Sinaloa y Durango: Carlos Calderón Vázquez, Hervey Rodríguez González, Claudia Castro Martínez y René Torres Ricario.
La investigación, aprobada en julio de 2024 y con finalización prevista para diciembre de este año, se estructura en seis áreas principales. Estas incluyen el estudio y preservación del material genético de agave, la caracterización de microorganismos involucrados en la producción de mezcal y la evaluación de la calidad del producto final.
Además, se abordan estrategias para el aprovechamiento sostenible de los subproductos generados en el proceso, su aplicación en la acuicultura y la producción de biocombustibles. Asimismo, se investiga la presencia de hongos fitopatógenos en el agave, se identifican bacterias clave en la fermentación del mezcal y se promueve la transferencia de conocimientos biotecnológicos a los productores, para su aplicación en el sector.
Ciencia a favor de una bebida milenaria
La doctora Vianey Marín Cevada, académica adscrita al Centro de Investigaciones en Ciencias Microbiológicas del ICUAP, explicó que el proyecto se desarrolla en San Bernardino Tepenene, municipio de San Juan Tzicatlacoyan; así como en Atlapulco y San Nicolás Huajuapan, en el municipio de Huehuetlán el Grande, comunidades en las cuales se conoció el estatus y características morfológicas del cultivo.
En la zona de estudio se identificaron cuatro especies principales de agave: papalometl, cupreata, espadín y espadilla. También se observó necrosis en las plantas por presencia de hongos patógenos, situación traducida en pérdidas para los productores. Por ejemplo, de 4 mil ejemplares sembrados hace cuatro años en un plantío ubicado en la comunidad de Tepenene, actualmente se conserva aproximadamente la mitad. Cabe mencionar que la madurez del maguey comprende un periodo de 7 a 12 años.
La científica nivel I del Sistema Nacional de Investigadores refirió que en las salidas de campo correspondientes a la época de lluvia se han aislado y purificado 183 muestras de microrganismos, predominantemente hongos, bajo un protocolo específico para evitar la contaminación cruzada e identificar el daño por microorganismos patógenos. Participaron estudiantes de la Licenciatura en Biotecnología y del posgrado en Ciencias Microbiológicas, quienes también tomaron muestras del suelo.
“Una parte del proyecto consiste en identificar a los hongos nocivos, por lo que se realizan las observaciones macro y microscópicas pertinentes. Igualmente, se pretende aislar a los organismos benéficos en una segunda etapa para usarlos contra Fusarium, un género de hongos fitopatógenos que impacta a más de 100 especies de plantas cultivadas, incluyendo cultivos de gran importancia económica”, indicó la especialista en biocontrol.
Marín Cevada, integrante del Cuerpo Académico BUAP-244 “Biotecnología microbiana”, señaló que otro de los objetivos del proyecto es construir un biosensor para detectar en etapas tempranas al hongo del género Fusarium, con el fin de impedir su propagación. Esta innovación tecnológica está a cargo del doctor Luis Ramiro Caso Vargas.
En cambio, los doctores Liliana López Pliego y Miguel Castañeda Lucio se enfocan en la identificación y caracterización de las bacterias y levaduras involucradas en el proceso de fermentación del agave mezcalero. “Actualmente el destilado se realiza de manera empírica, por lo que los maestros mezcaleros dependen de la evaluación sensorial -mediante el olfato y la degustación- para eliminar las fracciones conocidas como puntas y colas, las cuales pueden afectar la calidad del producto, conservando únicamente la porción intermedia del destilado”.
Para optimizar el proceso de destilado, “se recolectaron muestras de las barricas con el objetivo de analizar los compuestos volátiles responsables de la aromatización y tonalidad del destilado. Este análisis permitirá identificar los perfiles químicos característicos y detectar posibles deficiencias en el proceso fermentativo”, expuso Vianey Marín Cevada, doctora en Ciencias (Microbiología) por la BUAP.
Por su parte, los investigadores del IPN valoran el aprovechamiento de biomasa vegetal para la obtención de biocombustibles, como una estrategia sustentable que permite reducir la dependencia de combustibles fósiles y aprovechar residuos agroindustriales. En este contexto, el agave se ha convertido en una materia prima prometedora debido a su alto contenido de carbohidratos, especialmente fructanos y celulosa, que pueden ser transformados en biocombustibles y compuestos de alto valor agregado, como el xilitol.
Asimismo, a partir de la recolección de material vegetativo llevan a cabo la identificación de los agaves a nivel molecular y genético, con el afán de estudiar y conservar el germoplasma de especies endémicas del estado de Puebla, ya que cuando la producción se desfasa los agricultores extraen agaves que merman la diversidad de la región.
De esta manera, los científicos de la BUAP y el IPN enfocan sus esfuerzos en compartir con los productores los avances científicos que den un valor agregado a la elaboración de mezcal en Puebla.
You may also like
-
Puebla tiene 300 nuevos policías graduados de su academia: Armenta
-
Prevén fuertes lluvias en Puebla capital este martes
-
Firman convenio la BUAP y el Colegio de Estudios Científicos y Tecnológicos de Puebla
-
SSP, SSC y GN mantendrán vigilancia permanente en el mercado Morelos
-
Arranca el programa “Armenta Contigo”